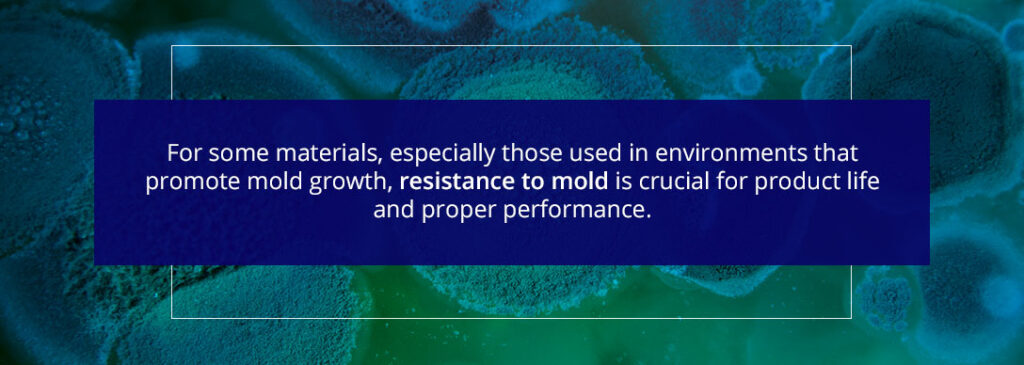
fungi under a microscope

Physical Testing
Improve Quality Control With Physical Testing and Analysis
The quality of your materials plays a direct role in your company's reputation. That's why physical testing is so important — it ensures your products reach a high level of quality so every client is impressed with product performance, reliability and durability.
In some cases, measuring the strength of physical materials can even be life-saving. At VTEC's standard testing lab, we offer accurate and fast physical testing for a wide range of test standards and materials at our ISO-accredited facility.

Understanding Physical Testing and Its Role in Quality Control
The term "physical testing" covers a range of tests that ensure different materials meet a certain standard. Depending on your industry, you may require access to electrical tests, fungal resistance tests or corrosion tests.
Because there are many factors at play during material production, physical testing helps ensure that everything has gone as intended. Physical tests protect you, your clients and their customers. They enhance your reputation as a company that can be trusted to keep its clients' best interests at the forefront of production.
The Importance of Physical Testing in Quality Control
Many modern industrial processes are automated and performed quickly. If there's an issue with machinery or a product specification, your company may not discover the issue right away. While some product defects are obvious, others aren't visual. Down the line, they can impact performance.
One of the most important roles of physical testing is to identify and rectify manufacturing defects before they have a significant impact on clients or your company. With physical testing in place, you can have confidence in your products because they are all tested before being sold.
The Impact of Physical Testing on Commercial Business Operations
Physical testing can be rolled into your product development and design flow. This ensures all products are appropriately tested without taking additional time after development. While testing does require time and equipment, it can save you time and finances in the long run.
Every business owner understands the value of risk mitigation. By preventing issues with physical testing processes, you can lessen the risk of legal allegations, broken business relationships and loss of reputation. Physical testing is absolutely essential for a well-managed company.
Effective Strategies for Overcoming Physical Testing Challenges in Manufacturing
While it may be important, physical testing comes with its own set of challenges. Testing equipment must be reliable to give accurate measurements and test results. Some types of tests can take a long time, slowing down production.
Thankfully, technological advancements have made the physical testing process much easier. As equipment has become more reliable and accurate, the testing process has become faster and more stable. By investing in the proper testing equipment, you can make this process painless and easy.
Industries the commonly use physical testing include:
- Aerospace
- Automotive
- Chemical
- Manufacturing
- Military and government
- Plastic
- Rail
Materials we analyze at our VTEC Laboratory include:
- Building Materials
- Chemicals
- Food
- Metals
- Nanomaterials
- Packaging
- Plastics
- Petroleum
- Polymers
- Raw materials
- And More
VTEC's Professional Standard Testing Lab: A Closer Look
With more than 30 years of experience and a team of industry veterans, VTEC provides comprehensive physical testing for companies around the globe. Our quick, two-week turnaround times also ensure you receive your results fast — our team can even expedite this process for time-sensitive cases.
All physical testing occurs at our ISO 17065- 17025- and 17020-accredited facility, which meets the testing standards of more than 20 different agencies. We also offer field testing at VTEC, giving you the option to have certain materials or equipment tested on-site by a qualified technician experienced with your industry and project needs.
Industries Benefiting From Physical Testing
Many manufacturers and commercial businesses benefit from physical testing. Here are just a few industries listed with some of their specific testing needs:
- Aerospace: Metals, petroleum and plastics
- Automotive: Plastics, polymers and petroleum
- Chemical: Chemicals and packaging
- Manufacturing: Food, metals and raw materials
- Military: Nanomaterials, chemicals and packaging
Over time, modern manufacturing processes have become mostly or even fully automated. With fewer people working in manufacturing, it's important to ensure there's a way to catch mistakes during the production process.
Without physical testing, industries wouldn't be able to provide products to customers with a high level of confidence. Physical tests function both to improve workflows and to ensure current methods are reaching the high standards of each company.
Comprehensive Material Analysis at VTEC Laboratory
Physical testing encompasses a wide range of analyses for many different kinds of materials. Your intended use of the material will determine what kinds of physical tests you need to perform. For example, materials for an engineering project might need to be tested for electrical, weathering and mechanical properties.
VTEC professional testing lab offers testing procedures for an extensive list of materials, including the following:
- Building materials
- Composites
- Chemicals
- Food
- Laminates
- Metals and alloys
- Nanomaterials
- Packaging
- Plastics
- Petroleum
- Polymers and resins
- Raw materials
- Structural materials
The specific testing procedures necessary for each material depend on the product's final use. For example, structural elements like metal and building materials for a bridge must be tested for corrosion, weathering and structural stability. Products like packaging will need to be tested for quality, but their structural safety is likely not a major concern.
Advantages of the VTEC Physical Testing Laboratory
Choosing VTEC Laboratories as your partner for physical tests and other testing services provides several benefits:
- Quick Turnaround Times: We value your time and deadlines. Our team delivers precise measurements within two weeks, so your company can continue moving forward with your project lineup. If you’re on a strict timeline, we’ll complete our physical analysis even sooner.
- Extensive Experience and Expertise: We have more than three decades of experience to offer, which lets us provide exceptional knowledge and solutions to you. For example, if you’re testing a material’s water absorption and are looking to decrease it, our team can help you design, build and install a performance-driven
- Versatile Tests and Testing Standards: Our experience also allows us to provide a range of physical testing standards. With our comprehensive list of testing standards, we’re able to meet the needs of various industries, from aerospace to plastic manufacturing, and provide not only physical testing, but also material and flammability analyses.
Contact VTEC Laboratories for a Physical Testing Quote
At VTEC Laboratories, we provide comprehensive physical testing for a range of testing standards, from the American Society for Testing and Materials (ASTM) to the International Organization for Standardization (ISO). Whether your organization needs to analyze a material’s susceptibility to corrosion or its fungal resistance, VTEC can provide the analysis you need at our physical testing laboratories.
Contact us online or call us at 718-542-8248 today for a physical testing quote.
Physical Testing and Sustainable Manufacturing
Some of the hallmarks of a sustainable company include reducing waste, recycling all possible materials and ensuring the production process doesn't cause actual harm to the environment. Physical testing plays an important role in sustainable manufacturing.
When physical testing is included as part of the production process, it can help reduce waste and preserve resources. It can also ensure that products meet environmental standards. Updated testing equipment can help you save time, reducing the resources needed to complete the production process.
VTEC has a full-time staff member, Dr. Sherri Schultz, who can help your company improve its sustainability practices through green technology. We can also support you in your journey to achieve a Green Certification for your product. Sustainability is one of our core values at VTEC.
In-Depth: Physical Testing Categories and Tests at VTEC
Different types of materials require different testing methods. Here's an in-depth overview of the different testing categories that VTEC can help your company cover. Click one of the links below or scroll to read over every category.
Water Exposure, Weathering, & Environmental Exposure
Corrosion and Immersion Testing
The corrosion resistance of a material plays an important role in how long it lasts, especially under harsh conditions. We conduct many different tests related to a material's resistance to corrosion and immersion. Some of the physical testing standards we provide for corrosion and immersion include:
- ASTM B117 - Salt Spray Test - ASTM B117 uses a salt spray apparatus to test the corrosion resistance of metals and coated metals. We perform the test in a chamber and use a salt fog to produce a corrosive environment. It is often used in conjunction with other exposure tests to corroborate the results.
- ASTM D4541 - Pull-off strength of coatings using portable adhesion-testers - This test determines the pull-off strength test, commonly referred to as adhesion, for coating systems on metal substrates. It uses portable adhesion-testers that apply a concentric load and counter load to a given surface. With this test, you can measure the greatest perpendicular force that a surface can withstand or determine whether a coated surface will stay intact at certain load criteria. This test will cause a fracture to occur along the weakest plane.
- ASTM E96 - Water vapor transmission - This examination tests the amount of water vapor that will transmit through permeable and semipermeable materials in given conditions. We test the material in conditions closest to those it will be used in. You can conduct E96 by applying water to one side of a surface or by creating conditions with low humidity on one side and high humidity on the other.
Some other physical testing standards we conduct in this area include:
- ASTM C800: Water repellency (11.8)
- ASTM C1016: Water absorption
- ASTM C1363 exclude: Water absorption
- ASTM D570: Water absorption
- ASTM E859: Air erosion of sprayed fire-resistive materials applied to structural members
- ASTM E937: Corrosion of steel by sprayed fire-resistive materials applied to structural members
- ASTM G8: Test methods for cathodic disbonding of pipeline coatings
- ASTM G12: Nondestructive measurement of film thickness of pipeline coatings on steel
- ASTM G14: Impact resistance of pipeline coatings
- ASTM G42: Test methods for cathodic disbonding of pipeline coatings subjected to elevated temps
- ASTM G62: Holiday detection in pipeline coatings
- MIL C-24643 Fluid immersion: JP5, Hydraulic fluids, etc.
Elemental Analysis and Testing
To determine what makes up a substance at a microscopic level, you need to run elemental analysis tests. At VTEC, we offer several tests that empower you to understand your products on an elemental level:
- EDS: Energy-dispersive X-ray spectroscopy (EDS) involves applying a high-energy beam of charged particles to a sample, which will excite the atoms within the material. This causes energy to be released as an X-ray, which an energy-dispersive spectrometer measures. By analyzing the energies of the X-rays, you can determine the elements that make up the sample.
- XRF: Another X-ray method for the identification and quantification of elements in a sample is X-ray fluorescence spectrometry (XRF). Applying high-energy X-rays or gamma rays excites a material and causes it to emit fluorescent, or secondary, X-rays. You can use these to perform elemental and chemical analyses. It is often used for testing metals, building materials, glass and ceramics, as well as for research.
- XRD: X-ray diffraction analysis (XRD) is used primarily for evaluating the molecular and atomic structures of crystals. In this test method, also called X-ray crystallography, the X-rays caused by the high-energy beam bounce back in many different directions because of the crystalline structures of the material. Analyzing the ways in which the rays diffract enables the crystallographer to determine the density of the electrons in the crystal and determine the positions of the crystal's atoms, their chemical bonds and other characteristics.
We can also perform a variety of other elemental analyses, including:
- ASTM D3171: This test determines the content of a composite material, such as the fiber content of resin-matrix composites using matrix digestion.
- Atomic absorption spectroscopy: This test is a spectroanalytical procedure for detecting the levels of chemical elements in a sample in parts per million.
- Electron microscopy: This analysis looks at materials using an electron microscope, which can determine levels of heavy metals and organic complexes.
- Infrared spectroscopy analysis: This test offers an analysis of organic material using infrared spectroscopy.
Water Exposure, Weathering and Environmental Exposure Testing Standards
How products react to weathering and other environmental impacts is important information. It determines how long the materials used will last and, sometimes, whether they can perform their intended functions properly.
Below are some of the tests related to water exposure, weathering and environmental exposure that we most frequently conduct:
- ASTM D523: This test measures the specular gloss of nonmetallic specimens. We obtain the gloss rating by comparing the reflectance of the material in question to that of a black glass standard. The test results will correlate with visual observations of shine from the same angles. D523 can also assess other characteristics such as reflection haze, the distinctness of reflected images and texture.
- ASTM D570: Using this test method, we can measure the rate of water absorption of plastics. If you have determined how water will impact a product, you can use the rate of water absorption to determine how it will perform if exposed to water or moisture. You can also use it as a control test for the uniformity of sheet, rod and tube arms on a finished product.
- ASTM G154: This test establishes standard practices for using a fluorescent ultraviolet (UV) lamp to test how a nonmetallic material reacts to exposure to UV light. Using this apparatus is meant to simulate the effects of typical everyday exposure. It can also replicate the impacts of sunlight through a window. Also known as the QUV test, G154 replaces ASTM G53.
Other environmental exposure tests we perform include:
- ASTM B117: Salt water exposure
- ASTM C473: Environmental exposure
- ASTM D573: Accelerated aging of rubber in an air oven
- ASTM D750: Carbon arc weathering
- ASTM D1037: Linear variation with a change in moisture content of wood-base fiber and particle materials
- ASTM D1149: Ozone resistance
- ASTM D1693: Environmental stress-cracking
- ASTM D2047: Static coefficient of friction of polished floor surfaces as measured by James Machine
- ASTM D2126: Thermal and humidity aging (dimensional stability section)
- ASTM D2842: Water absorption of cellular plastics
- ASTM D4103: Practice for preparation of substrate surfaces for coefficient of friction testing
- ASTM D4742: O2 stability of gasoline engine oils by Thin Film Oxygen Uptake Testing (TFOUT)
- ASTM E424, Method A: Solar energy transmittance and reflectance of sheet materials
- ASTM E937: Salt water exposure corrosion
- ASTM F1344: Specification for rubber floor tile
- ASTM G21: Fungus exposure
- ASTM G22: Bacterial exposure
- ASTM G26: Xenon-Arc light and water exposure for nonmetals
- ASTM G53: QUV light and condensation exposure for nonmetals
- ASTM G155: Xenon ARC
Fungal Resistance Testing
For some materials, especially those used in environments that promote mold growth, resistance to mold is crucial for product life and proper performance. We offer the following product testing services for measuring fungal resistance:
- ASTM D3273: This test measures resistance to mold growth on the surface of interior coatings, such as paint films, using an environmental chamber. It allows you to determine within a four-week period the relative resistance of these coatings to mold and mildew. It is useful for assessing a product's resistance to fungi growth, its performance under mold-promoting conditions and the compounds that can slow fungi growth.
- ASTM G21: This test enables you to measure the resistance of synthetic polymeric materials to fungi and determine the effects of fungi on such materials. Synthetic polymers themselves are usually relatively resistant to fungi, so it is often the other components, such as colorants, cellulosics, stabilizers and lubricants that create the vulnerabilities. This test can help you choose which of these components to use.
Other fungal resistance tests we offer include:
- ASTM D2017: Accelerated wood decay
- ASTM D2020: Mildew (fungal) resistance of paper and paperboard
- ASTM G22: Resistance to bacteria
Physical Testing Standards for Luminance Testing
Lighting is often critical to safety, so it is important to perform luminance tests on photoluminescent products. We can also conduct numerous luminescence tests:
- ISO 15370: The ISO 15370 standard from the International Organization for Standardization sets requirements for the approval, installation and maintenance of low-location lighting systems on passenger ships, as defined by the International Convention for the Safety of Life at Sea and the IMO International Code for Fire Safety Systems.
- ISO 17398: This test is a specification for safety colors and safety signs regarding classification, performance, durability and expected service life. It establishes requirements related to the service environment, materials, photometric properties, method of illumination and other characteristics.
- ASTM E2072: A specification that establishes minimum luminance values for photoluminescent and phosphorescent safety markings
-
Physical Testing Standards Offered for Mechanical and Structural Properties
We offer many different tests for a range of standards regarding the mechanical and structural properties of materials in construction and many other industries:
- ASTM D412: Also known as the Die C-tensile properties, this process is used to evaluate the tensile properties of vulcanized thermoset rubbers and thermoplastic elastomers to help ensure that the products where they are used perform correctly. It includes two methods, one which uses dumbbell and straight section specimens and one that uses cut ring specimens.
- ASTM D638: This test is used to evaluate the tensile properties of unreinforced and reinforced plastics. We conduct the test using plastics in the form of dumbbell-shaped test samples under predefined conditions.
- ASTM D790: This test evaluates the flexural properties of unreinforced and reinforced plastics and electrical insulating materials. The properties tested include flexural stress, strength and strain, as well as modulus of elasticity and others. This test is especially useful for quality control and specification purposes.
We also can conduct a wide range of other structural and mechanical property tests:- ASTM C109: Test for determining the compressive strength of hydraulic cement and other mortars.
- ASTM C338: Test for determining the softening point of glass.
- ASTM D256, Method A: Standard tests for determining the Izod pendulum impact resistance of plastics.
- ASTM D445: Determines kinematic viscosity of transparent and opaque liquid petroleum products and calculates the dynamic viscosity.
- ASTM D624: Test for determining tear strength of conventional vulcanized rubber and thermoplastic elastomers.
- ASTM D695: Test for determining the compressive properties of unreinforced and reinforced rigid plastics.
- ASTM D696: Determines the coefficient of linear thermal expansion for various plastic materials that have coefficients of expansion above one µm/(m.°C). This test is conducted with a vitreous silica dilatometer. The creep, elastic strain rate or both under the testing conditions must be negligible so that it does not impact the accuracy of the test.
- ASTM D751: Tests for evaluating the physical properties, including strip tensile, grab tensile, tongue tear, low-temperature bend and adhesion for coated fabrics.
- ASTM D952: Test for determining bond or cohesive strength of sheet plastics and electrical insulating material.
- ASTM D1002: Test for determining apparent shear strengths of adhesives for bonding metals.
- ASTM D1239: Test of resistance to extraction by chemicals for plastic films.
- ASTM D1388: Determines bending length and flexure rigidity of fabrics to evaluate stiffness.
- ASTM D1474: Test for determining indentation hardness of organic coatings, such as dried paint, varnish and lacquer coatings.
- ASTM D1599: Evaluate the short-term hydraulic resistance of plastic pipes, tubes and fittings.
- ASTM D1621: Test for evaluating compressive strength of rigid cellular plastics.
- ASTM D1622: Test for evaluating the apparent density of rigid cellular plastics.
- ASTM D1822: Tensile-impact energy to rupture plastics and electrical insulating materials.
- ASTM D2136: Low-temperature bend test for coated fabrics.
- ASTM D2240: Tests for durometer hardness of rubber materials.
- ASTM D2303: Test of liquid-contaminant, inclined-plane tracking and erosion of insulating materials.
- ASTM D2563: Method for classifying visual defects in glass-reinforced plastic laminate parts.
- ASTM D2583: A test method for indentation hardness of rigid plastics using a Barcol Impressor.
- ASTM D3039: Tensile properties of polymer matrix composite materials reinforced by high-modulus fibers.
- ASTM D3359: Test for evaluating the adhesion of relatively ductile coating films to metallic substrates.
- ASTM D3410: Compressive properties of polymer matrix composite materials reinforced by high-modulus fibers.
- ASTM D3418: Test to determine transition temperatures and enthalpies of fusion and crystallization of polymers using differential scanning calorimetry.
- ASTM D3574: Test methods for evaluating the quality of flexible cellular materials.
- ASTM D4060: Test for assessing abrasion resistance of organic coating using the Taber Abraser.
- ASTM D4226, Methods A and B: Test of impact resistance of rigid PVC building products.
- ASTM D4565: Cold bend testing for insulations and jackets for telecommunications wire and cable.
- ASTM E23: Notched-bar impact testing of metallic materials using the Charpy test and Izod test.
- ASTM E228: Test of linear thermal expansion of solid materials using a dilatometer.
- ASTM E303: Method for measuring surface frictional properties using the British pendulum skid resistance tester.
- ASTM E761: Compressive strength test for SFRM applied to structural members.
- ASTM E831: Linear thermal expansion test for solid materials by thermomechanical analysis.
- ASTM E1131: A test method for determining the amount of highly volatile matter, medium-volatility matter, combustible material and ash content in compounds through a general technique incorporating thermogravimetry.
- ASTM E1782: Test for determining vapor pressure of pure liquids or melts by thermal analysis.
- ASTM G56: Method for determining the abrasiveness of ink-impregnated fabric printer ribbons and other web materials using a sliding wear test.
- DIN 51900, Method 2: Test of the gross calorific value and net calorific value of solid and liquid fuels.
- ISO 1716: Reaction to fire tests and determination of the gross heat of combustion, or calorific value, materials for solid products, such as building materials.
- ISO 8256: Methods for testing the tensile-impact strength of plastics.
- MIL-P-8053C: Test of shear strength of plywood and metal-to-plywood bonds.
- Thermogravimetric analysis: Analysis of thermal properties that involves examining the mass changes of a sample due to temperature and time.
- Differential scanning calorimetry: Analysis of thermal properties by measuring the amount of heat required to increase the temperature of a sample.
- Differential thermal analysis: Analysis of thermal properties by observing the thermal behavior of a sample as it heats up.
- Withdrawn standards with no replacements: Sometimes, standards are withdrawn, meaning they're no longer relevant at the international level. These standards will no longer be maintained or updated.
Thermal Conductivity and Analysis
We offer a wide range of thermal analysis services, which include the following:
- ASTM C518: This test involves using a heat flowmeter to test and quickly determine the steady-state thermal transmission properties of materials such as thermal insulations. When the apparatus has been calibrated correctly, this test has high degrees of accuracy.
- ASTM C177: This test method involves the measurement of steady-state heat flux through thermal insulation materials using a guarded hot plate apparatus. It is used for flat, homogeneous specimens. You can use either single-sided or double-sided methods of measurement and apply heat either horizontally or vertically.
- ASTM C201: This test measures thermal conductivity for refractories.
We also perform these thermal conductivity analyses:
- ASTM C335: Test of heat transfer properties for horizontal pipe insulation.
- ASTM C411: Method for evaluating the hot surface performance of high-temperature thermal insulation.
- ASTM E1225: Test for determining the thermal conductivity of solids using a guarded-comparative-longitudinal heat flow technique.
The following standards are withdrawn and do not currently have replacements:
- ASTM F814: Test for assessing the specific optical density of smoke created by materials used in the aerospace industry
- ASTM G22: Processes for determining the impacts of bacteria on the properties of plastic products
- ASTM D2017: Test for assessing the natural decay resistance of wood
- ASTM D2020: Test for assessing the mildew, or fungus, resistance of paper and paperboard
- ASTM C351: Test of the mean specific heat of thermal insulation
- ASTM D1055: Specifications for flexible cellular rubber products, including latex foam rubbers, but not sponge or expanded rubbers
- ASTM D4518: Test for measuring static friction of coating surfaces
- ASTM D5942: Test of Charpy impact strength
Invest in Your Products With Physical Testing
Physical testing can help your company turn out top-notch products every time. Testing company materials will improve your reputation, create satisfied customers and can help you streamline your production process. When applied well, physical testing can also have a positive environmental impact.
When you're ready to invest in physical testing, reach out to VTEC Laboratories. We have the expertise and testing range you need to upscale your production process and improve your product range. Get a quote from VTEC today by contacting us online or calling us at 718-542-8248!
Connect With VTEC Laboratories for a Physical Testing Quote
At VTEC Laboratories, we provide comprehensive physical testing for a range of testing standards, from the ASTM International (formally the American Society for Testing and Materials) to the International Organization for Standardization (ISO). Whether your organization needs to analyze a material's susceptibility to corrosion or its fungal resistance, VTEC can provide the analysis you need at our physical material testing laboratories.
Contact us online or call us at 718-542-8248 today for a physical testing quote.
Contact VTEC Laboratories for a Physical Testing Quote
At VTEC Laboratories, we provide comprehensive physical testing for a range of testing standards, from the American Society for Testing and Materials (ASTM) to the International Standards Organization (ISO). Whether your organization needs to analyze a material’s corrosion or fungal resistance, VTEC can provide the analysis you need.
Contact us online, or call us at (718) 542-8248 today for a physical testing quote.